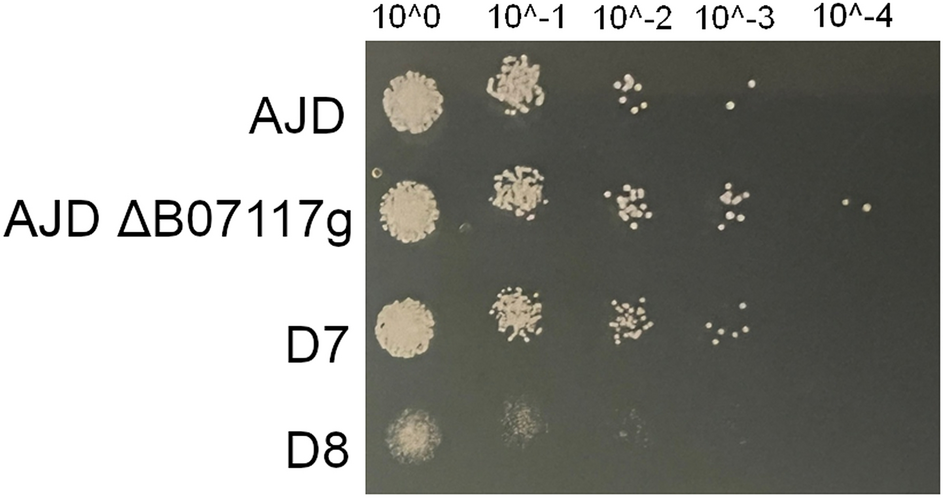
Figure 5

Figure 5
From: In-depth analysis of erythrose reductase homologs in Yarrowia lipolytica
Spot-test analysis of the AJD, AJD ΔB07117g, D7 and D8 strains on YNB medium with 2% glycerol and addition of 1 M NaCl. The photo was taken after 72 h of growth at 28 °C. Initial OD was set at 0.2, successive dilutions are indicated on the top.